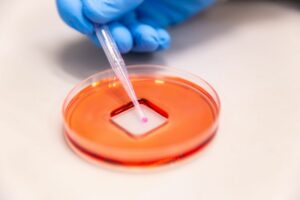

New findings on the effects of Covid-19 on the colon: Although SARS-CoV-2 infections mainly attack the lungs, in many cases they can also damage other organs, such as the colon: around 60% of patients experienced digestive tract impacts. Researchers at MedUni Vienna have analysed the manifestations of Covid-19 in the lungs and colon and pinpointed […]
The effects of Covid-19 on the colon